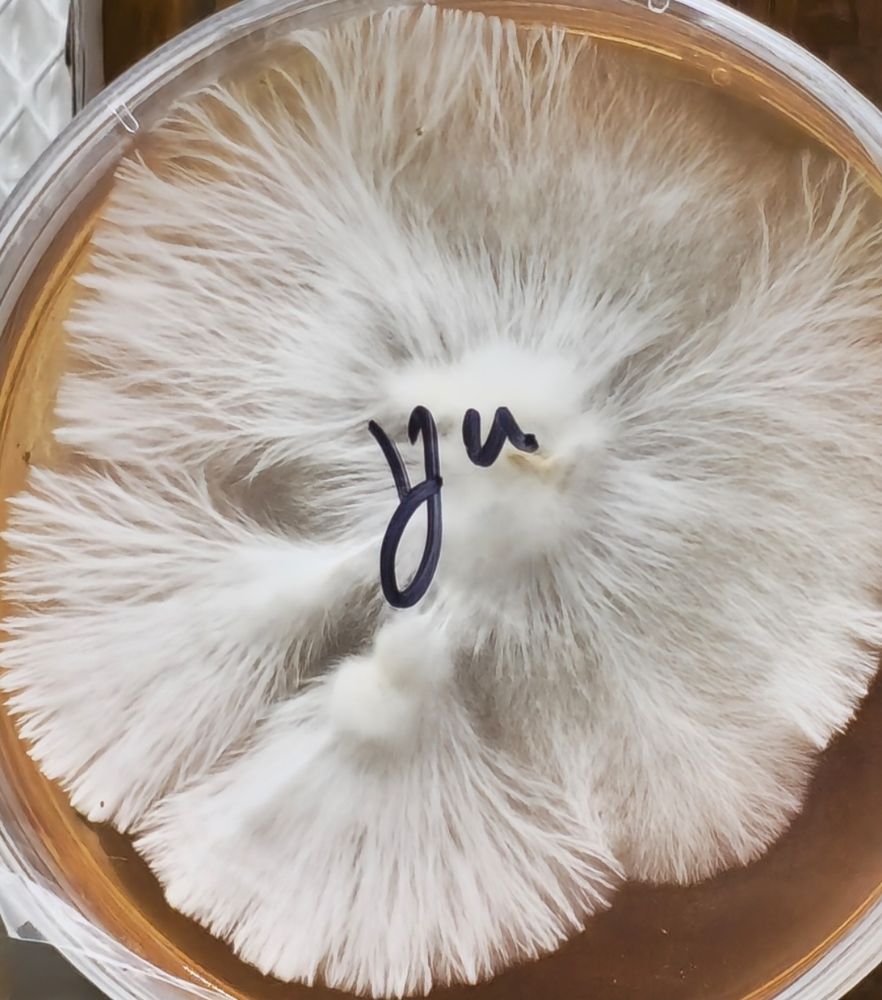
Post image

Galactic Gorilla. #mycology #fungifriends #fungi #psychedelicresearch #mushroommagic #mushrooms
28.01.2025 21:46 — 👍 17 🔁 0 💬 0 📌 0@growthatfire.bsky.social
Mycology Colorado. #colorado #mycology Taspores.com

Galactic Gorilla. #mycology #fungifriends #fungi #psychedelicresearch #mushroommagic #mushrooms
28.01.2025 21:46 — 👍 17 🔁 0 💬 0 📌 0
Who likes yellow? #fungifriends #colorado #growing #mycelium #agar
19.12.2024 06:21 — 👍 9 🔁 0 💬 0 📌 0
Struck gold while photoing my buddy's crystal skull. #s23ultra #lightroom #photography
11.12.2024 00:25 — 👍 3 🔁 0 💬 0 📌 0
Organic vegan cultivation of Enigma mushroom strain.

Organic vegan cultivation of Enigma mushroom strain

Organic vegan cultivation of Enigma mushroom strain
Enigma. #photography #mycology #mushrooms #mushroom #fungi #fungifriends #Enigma #colorado #loveland #boulder #denver #loveland #fortcollins #growyourown
10.12.2024 01:52 — 👍 12 🔁 0 💬 0 📌 0

Ladies and Gentlemen.... Enigma!!! #mushrooms #fungifriends #colorado #loveland #grow #growyourown
08.12.2024 04:30 — 👍 11 🔁 0 💬 0 📌 0
Enigma #mushrooms #fungi #fungifriends #rare #genetics #colorado
01.12.2024 04:44 — 👍 7 🔁 0 💬 0 📌 0
I had to color correct it.
29.11.2024 23:47 — 👍 0 🔁 0 💬 0 📌 0
Another floral riptide for the day. 🌸 #mushrooms #colorado #growing #mycelium #agar #fungifriends
29.11.2024 22:18 — 👍 4 🔁 0 💬 0 📌 0
A little riptide today. Almost a flower 🌸 #mushrooms #colorado #growing #mycelium #agar #fungifriends
29.11.2024 19:09 — 👍 5 🔁 0 💬 2 📌 0
Happy Turkey Day everyone! blue meanie closeup #macro #mycelium #mycology #fungifriends #colorado #mushrooms #agar
29.11.2024 00:49 — 👍 5 🔁 0 💬 0 📌 0
Feeling cute, might delete later. #enigma #mushrooms #mycology #colorado
27.11.2024 03:15 — 👍 1 🔁 0 💬 0 📌 0
Reishi roped out and ready for some transfers. #mushrooms #colorado #stayhealthy
26.11.2024 19:19 — 👍 8 🔁 0 💬 1 📌 0
Mean looking Jack Frost Isolate liquid cultures #mushrooms #liquidculture #myco #mycology #colorado
25.11.2024 21:53 — 👍 1 🔁 0 💬 0 📌 0
Some incredible growth with this Yellow Umbo isolation. #mushrooms #colorado #mycology
23.11.2024 21:03 — 👍 1 🔁 0 💬 0 📌 0